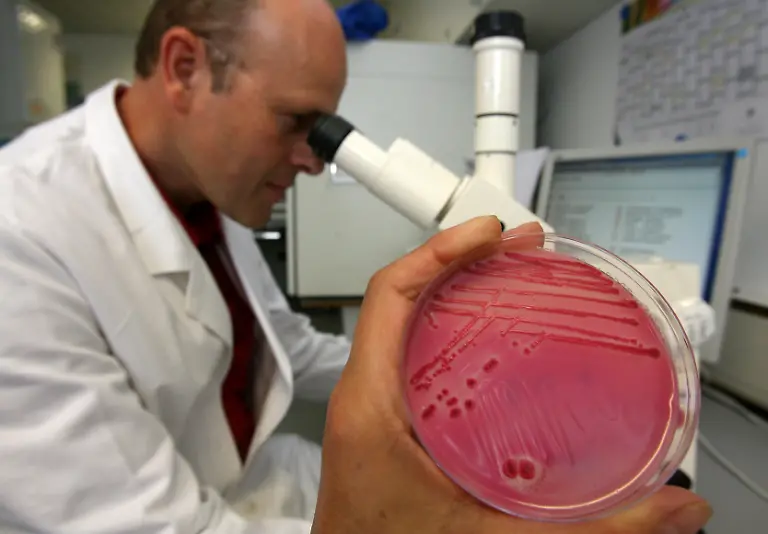
lebensmittel

Bilderserien
"Ich bin ein Mischwesen"Die skurrilsten Dopingausreden
30.09.2010, 10:44 Uhr
Jetzt also das Essen. War verunreinigt, mit dem Kälbermastmittel. Sagt Radprofi Alberto Contador. Und will so erklären, warum die Dopingfahnder Clenbuterol in seinem Urin gefunden haben. Das klingt originell. Es gibt aber Kollegen, die bei der Suche nach Erklärungen wesentlich kreativer sind.